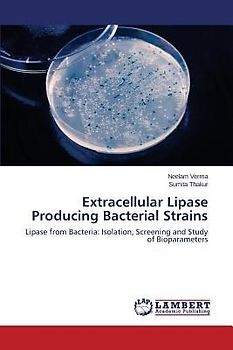

iPhoneAlle anzeigen
iPhone 11iPhone 11 ProiPhone 11 Pro MaxiPhone 12iPhone 12 ProiPhone 12 Pro MaxiPhone 12 miniiPhone 13iPhone 13 ProiPhone 13 Pro MaxiPhone 13 miniiPhone 14iPhone 14 PlusiPhone 14 ProiPhone 14 Pro MaxiPhone 15iPhone 15 PlusiPhone 15 ProiPhone 15 Pro MaxiPhone 16iPhone 16 PlusiPhone 16 ProiPhone 16 Pro MaxiPhone 16eiPhone 5iPhone 5CiPhone 5SiPhone 6iPhone 6 PlusiPhone 6SiPhone 6S PlusiPhone 7iPhone 7 PlusiPhone 8iPhone 8 PlusiPhone SEiPhone SE 2020iPhone SE 2022iPhone XiPhone XRiPhone XSiPhone XS Max
NokiaAlle anzeigen
108 Reihe220 Reihe225 Reihe2600 classic Reihe2680 slide Reihe2710 Reihe3120 classic Reihe3220 Reihe500 Reihe515 Reihe5230 Reihe603 Reihe6131 Reihe6200 Reihe6300 Reihe6500 Reihe6700 Reihe700 Reihe7200 Reihe8310 ReiheAshaC1C2C3C5C6C7E51E52E6E63E65E7E71E72N73N8N9N95N97Nokia 3Nokia 4.2Nokia 5Nokia 6Nokia 7Nokia 8SiroccoWeitere ModelleXX2X3X6XLXpressMusic
Galaxy A-SerieAlle anzeigen
Galaxy A12Galaxy A13Galaxy A13 5GGalaxy A14Galaxy A15Galaxy A16Galaxy A17 5GGalaxy A20eGalaxy A21Galaxy A22Galaxy A23Galaxy A24Galaxy A25Galaxy A26 5GGalaxy A3Galaxy A32Galaxy A33Galaxy A34Galaxy A35Galaxy A36 5GGalaxy A40Galaxy A41Galaxy A42Galaxy A50Galaxy A51Galaxy A52Galaxy A53Galaxy A54Galaxy A55Galaxy A56 5GGalaxy A70Galaxy A71Galaxy A72
Redmi SeriesAlle anzeigen
Redmi 10Redmi 13CRedmi 15 5GRedmi Note 10Redmi Note 10 ProRedmi Note 11Redmi Note 11 ProRedmi Note 11 Pro Plus 5GRedmi Note 11sRedmi Note 12Redmi Note 12 5GRedmi Note 12 ProRedmi Note 12 Pro 5GRedmi Note 12 Pro PlusRedmi Note 13Redmi Note 13 5GRedmi Note 13 ProRedmi Note 13 Pro PlusRedmi Note 14Redmi Note 14 Pro PlusRedmi Note 8Redmi Note 8 ProRedmi Note 9Redmi Note 9 Pro
Gebrauchte Bücher von Verma, Neelam bei rebuy
… Von Expert:innen geprüfte Verma, Neelam-Bücher. Entdecke unsere Riesenauswahl und bestelle ohne Risiko. Nachhaltig und günstig!
… Von Expert:innen geprüfte Verma, Neelam-Bücher. Entdecke unsere Riesenauswahl und bestelle ohne Risiko. Nachhaltig und günstig!

Extracellular Lipase Producing Bacterial Strains
★★★★★
☆☆☆☆☆ Nur als Neuware

El grafeno en la investigación del agua
★★★★★
☆☆☆☆☆ Lieber Geld verdienen als ausgeben?
Verkauf Elektronik und Medien ganz einfach an uns
Versand immer kostenlos und versichert 100 % Löschung deiner Daten Erfahrung und Sicherheit seit 2004
Der Streichpreis bezieht sich auf die unverbindliche Preisempfehlung des Herstellers, den aktuellen durchschnittlichen Neupreis des Produktes bei idealo Deutschland, oder bei Büchern auf den festgelegten Preis für Neuware.
